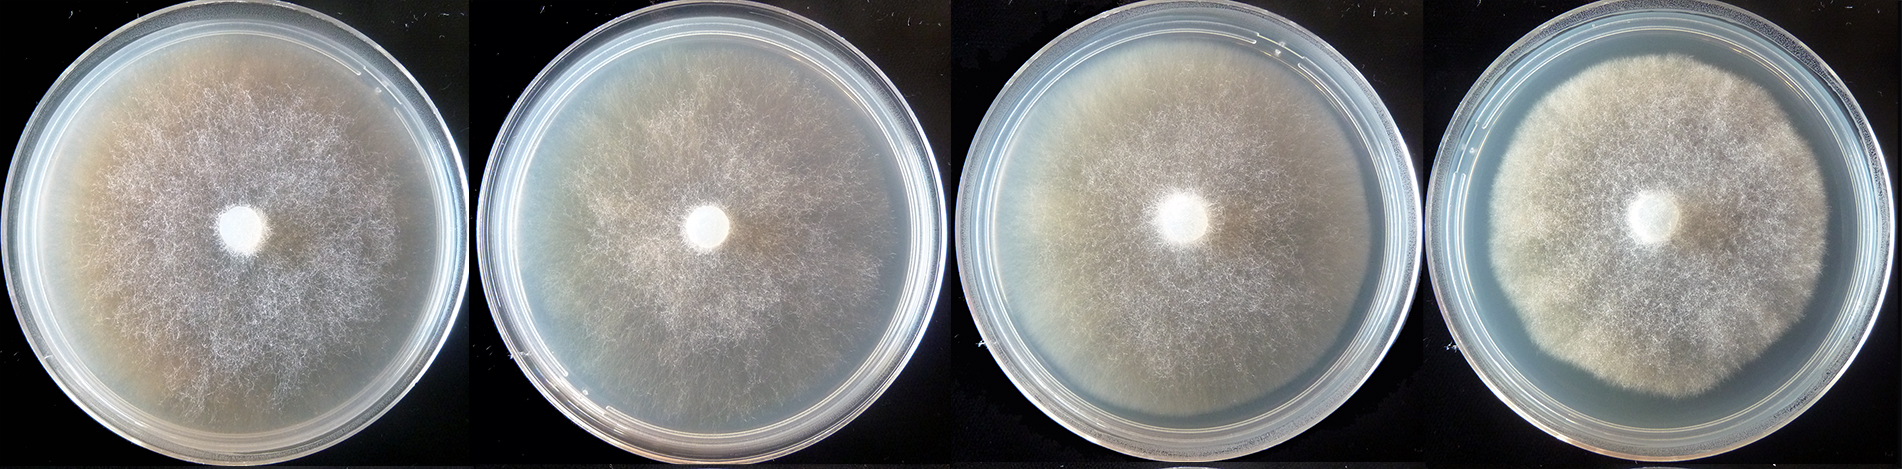

Phytophthora balyanboodja
|
Phytophthora spp. in subclade 6a: portion of the seven-loci ML phylogeny featuring the type cultures of 212 described species (by T. Bourret). Notice the position of P. balyanboodja Ex-type CBS 143058 = S&T BL 186. Gloria Abad, USDA S&T.
|
|
Phytophthora spp. in subclade 6a: Morphological Tabular key (PDF) and Tabular key legends (PDF) in IDphy2 KEY SECTION. Notice the data of P. balyanboodja Ex-type CBS 143058 = S&T BL 186. Gloria Abad, USDA S&T.
|
|
colony morphology after 5 d growth at 20ºC on CA, V8 agar, MEA, and PDA (from left to right) |
|
sporangia typically ovoid and nonpapillate, although many had apical protrusions which continued to grow leading to direct germination of sporangia; scale bar = 25µm |
|
proliferation in chains, both nested and extended; scale bar = 25µm |
Name and publication
Phytophthora balyanboodja T.I. Burgess (2018)
Burgess TI, Simamora AV, White D, Wiliams B, Schwager M, Stukely MJC, Hardy GE StJ. 2018. New species from Phytophthora Clade clade:
a taxonomic group of organisms classified together on the basis of homologous features traced to a common ancestor
6a: evidence for recent radiation. Persoonia 41: 1–17.
Corresponding author: tburgess@murdoch.edu.au
Nomenclature
from Burgess et al. (2018)
Mycobank
Etymology
named for wetlands in Noongar (local Aboriginal) language
Typification
Type: AUSTRALIA, Western Australia, Alfred Cove, from rhizosphere soil of mixed native vegetation, isolated by the VHS, 2015 (holotype MURU 475, dried culture on V8A, Herbarium of Murdoch University, Western Australia)
Ex-type: CBS 143058
Sequences for ex-type in original manuscript: ITS KJ372258 (Phytophthora taxon cyperaceae strain VHS25675 R1C)
Phytophthora balyanboodja strain VHS25675 R1: TUB MF326806, HSP MF326892, COX MF326862 and NADH MF326927
Ex-type in other collections
(ET) CBS 143058, VHS25675, R1C, S&T BL 186 (Abad)
Molecular identification
Voucher sequences for barcoding genes (ITS rDNA and COI) of the ex-type (see Molecular protocols page)
Phytophthora balyanboodja isolate VHS25675 R1C ITS rDNA KJ372258
Phytophthora balyanboodja isolate CPHST BL186 COI MH477741
Voucher sequences for Molecular Toolbox with seven genes (ITS, β-tub, COI, EF1α, HSP90, L10, and YPT1
(see Molecular protocols page) (In Progress)
Voucher sequences for Metabarcoding High-throughput Sequencing (HTS) Technologies [Molecular Operational Taxonomic Unit (MOTU)]
(see Molecular protocols page) (In Progress)
Sequences with multiple genes for ex-type in other sources
- NCBI: Phytophthora balyanboodja CPHST BL 186
- NCBI: Phytophthora balyanboodja VHS 25675R1
- EPPO-Q-bank: Phytophthora balyanboodja
- BOLDSYSTEMS: Phytophthora balyanboodja (barcoding COI & ITS)
Position in multigenic phylogeny with 7 genes (ITS, β-tub, COI, EF1α, HSP90, L10, and YPT1)
Clade 6a
Morphological identification
Colonies and cardinal temperatures
Colony colony:
assemblage of hyphae which usually develops form a single source and grows in a coordinated way
morphology on V8, PDA, MEA, and CA are woolly and uniform. Growth is fast on all media. Minimum growth temperature 4°C, optimum 32.5°C, maximum greater than 37.5°C.
Conditions for growth and sporulation
SporangiaSporangia:
sac within which zoospores form, especially when water is cooled to about 10°C below ambient temperature; in solid substrates, sporangia usually germinate by germ tubes
are produced in water cultures (soil extract or river water) and not observed in solid media. OogoniaOogonia:
the female gametangium in which the oospore forms after fertilization by the antheridium
are not observed in single culture or when paired with tester strains.
Asexual phase
SporangiaSporangia:
sac within which zoospores form, especially when water is cooled to about 10°C below ambient temperature; in solid substrates, sporangia usually germinate by germ tubes
are nonpapillatenonpapillate:
pertaining to the production of a non-distinct, or inconspicuous, papilla at the distal end of the sporangium (cf. papillate and semipapillate)
, persistentpersistent:
pertaining to sporangia that remain attached to the sporangiophore and do not separate or detach easily (cf. caducous)
, exclusively ovoidovoid:
egg-shaped, with the widest part at the base of the sporangium and the narrow part at the apex
to elongated ovoidovoid:
egg-shaped, with the widest part at the base of the sporangium and the narrow part at the apex
with average dimensions of 63.3 ± 8.3 x 39.7 ± 5.8 µm (overall range 40.9–75.7 x 21.2–51.1 µm). Sporangiophores are simple, and internal proliferationinternal proliferation:
internal proliferation occurs when the sporangiophore continues to grow through an empty sporangium
both nested and extended occurred in chains. Hyphal swellings absent. ChlamydosporesChlamydospores:
an asexual spore with a thickened inner wall that is delimited from the mycelium by a septum; may be terminal or intercalary, and survives for long periods in soil
absent.
Sexual phase
Sterile in culture.
Most typical characters
The most typical features for Phytophthora balyanboodja are its uniform sporangiasporangia:
sac within which zoospores form, especially when water is cooled to about 10°C below ambient temperature; in solid substrates, sporangia usually germinate by germ tubes
proliferating in chains, as well as its fast growth rate and high temperature optima.
Specimen(s) evaluated
Australia, Western Australia, Alfred Cove, from rhizosphere soil of mixed native vegetation, isolated by the VHS, 2015, culture ex-type CBS 143058 = VHS23675-R1; VHS23675-R3
Hosts and distribution
Not found in U.S. National Fungus Collections Nomenclature Database as of June 20, 2018.
Additional references and links
- SMML USDA-ARS: Phytophthora balyanboodja
- EPPO Global Database: Phytophthora balyanboodja
- Forest Phytophthoras of the world: Phytophthora balyanboodja
- CABI Digital Library: Phytophthora balyanboodja
- Encyclopedia of Life (EOL): Phytophthora balyanboodja
- Index Fungorum (IF): Phytophthora balyanboodja
- Google All Phytophthora balyanboodja
- Google Images Phytophthora balyanboodja
- Google Scholar Phytophthora balyanboodja
Fact sheet authors
Treena Burgess, Ph.D., Phytophthora Science and Management, Harry Butler Institute, Murdoch University, Australia
Z. Gloria Abad, Ph.D., USDA-APHIS-PPQ-S&T Plant Pathogen Confirmatory Diagnostics Laboratory (PPCDL), United States of America.